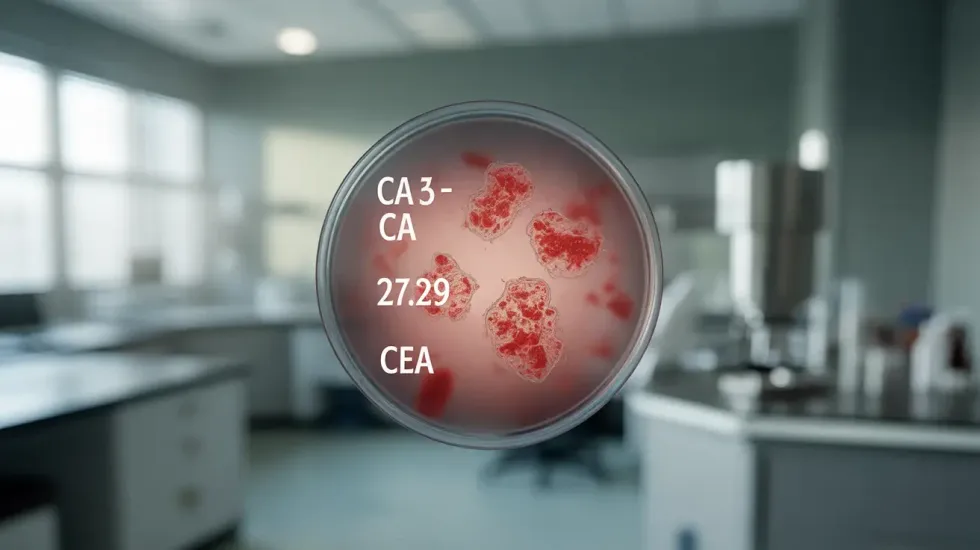

Kur dhe cilët tumor markerë përdoren më shpesh dhe sa të besueshme janë këto teste

Besueshmëria e treguesve të tumorit (tumor markerëve) varet nga vetë markeri që matet, nga lloji i kancerit dhe nga faza e sëmundjes
Tumor markerët janë substanca që mund të gjenden në gjak, urinë ose në inde, te personat që vuajnë nga disa lloje kanceri. Zakonisht i prodhojnë vetë qelizat tumorale, por ndonjëherë ato krijohen edhe nga vetë trupi si reagim ndaj pranisë së tumorit ose gjendjeve të tjera beninje.
Sa janë të besueshëm tumor markerët?
Vlerat e rritura të këtyre treguesve mund të sinjalizojnë praninë e një procesi malign, por nuk janë të mjaftueshme për të vendosur diagnozën e kancerit. Te disa persona me kancer, markerët mund të mbeten brenda normës, veçanërisht në fazat e hershme të sëmundjes, ndërsa te të tjerë mund të rriten për shkak të infeksioneve, inflamacioneve apo sëmundjeve të padëmshme që nuk kanë lidhje me tumorin.
Për këtë arsye, mjekët i interpretojnë rezultatet gjithmonë në kontekstin e pamjes klinike dhe rezultateve shtesë diagnostike, si biopsia, ultrazëri apo rezonanca magnetike.
Besueshmëria varet nga markeri dhe nga lloji i kancerit: disa janë shumë specifikë dhe të vlefshëm për ndjekjen e tumoreve të caktuara (si PSA për kancerin e prostatës), ndërsa të tjerë janë më pak precizë pasi mund të rriten edhe në sëmundje beninje.
Në përgjithësi, tumor markerët nuk janë mjaft të ndjeshëm apo specifikë për zbulimin e hershëm të kancerit te personat pa simptoma. Ato mund të japin rezultate fals negativë (kanceri ekziston, por markeri është normal) ose fals pozitivë. Prandaj, ato nuk përdoren për kontrolle rutinë parandaluese, por si mjete shtesë për diagnostikë, vlerësim të suksesit të terapisë dhe për zbulimin e hershëm të rikthimit të sëmundjes, transmeton Telegrafi.
Kur duhet bërë testi i treguesve të tumorit?
Në ndryshim nga metodat imazherike, tumor markerët mund të ndihmojnë në zbulimin e hershëm të ndryshimeve gjatë sëmundjes, por nuk mund t’i zëvendësojnë plotësisht metodat diagnostike si CT, MRI apo biopsia.
Ata përdoren kryesisht për:
- përcaktimin e stadit të sëmundjes dhe parashikimin e ecurisë,
- zgjedhjen e terapive, sidomos të atyre të synuara gjenetikisht,
- ndjekjen e efektivitetit të trajtimit dhe zbulimin e rikthimit të tumorit (nëse vlerat bien, zakonisht terapia po funksionon),
- zbulimin e recidivit – rritja e markereve pas trajtimit mund të jetë shenjë e parë e rikthimit të sëmundjes.
Cilat janë treguesit e tumorit më të përdorur në praktikë?
Analizat për tumor markerë mund të kryhen nga gjakut, urina ose indet. Zakonisht merren nga gjaku venoz, pa përgatitje të veçantë. Në disa raste, analizat bëhen nga urina ose nga mostra të indeve të marra me biopsi.
Ekzistojnë dhjetëra tregues të ndryshëm, por në praktikën e përditshme përdoret vetëm një pjesë e tyre:
- CA 125 – ndër më të njohurit, përdoret në ndjekjen e kancerit të vezoreve. Vlerat e rritura mund të tregojnë për këtë sëmundje, por mund të rriten edhe për arsye beninje (endometriozë, kiste ovariane, menstruacion, inflamacion). Përdoret kryesisht për ndjekje dhe jo për diagnostikë të hershme.
- CEA (antigjeni karcinoembrional) – mund të rritet te kanceri i zorrës së trashë, pankreasit, stomakut dhe mushkërive, por edhe te duhanpirësit apo personat me sëmundje inflamatore të zorrëve. Përdoret për të ndjekur suksesin e terapisë dhe për të zbuluar rikthimin e tumorit.
- CA 19-9 – lidhet kryesisht me kancerin e pankreasit dhe të kanaleve biliare.
- CA 15-3 – përdoret për ndjekjen e kancerit të gjirit.
- PSA (antigjeni specifik i prostatës) – përdoret për vlerësimin e kancerit të prostatës, por mund të jetë i rritur edhe në raste të zmadhimit beninj apo infeksioneve të prostatës.
- AFP (alfa-fetoproteina) – rritet te kanceri i mëlçisë dhe te disa tumore të qelizave germinale.
- Beta-hCG – mund të tregojë për koriokarcinomën ose tumoret testikulare.
Në ditët e sotme, disa tregues nuk maten vetëm në gjak, por drejt e në indin tumoror, duke dhënë informacion për ndryshimet gjenetike dhe mundësinë e përdorimit të terapive të synuara. Shembuj të tillë janë: HER2/neu (në kancerin e gjirit dhe stomakut), EGFR dhe ALK (në kancerin e mushkërive), si dhe BRCA1/BRCA2 (në kancerin e gjirit dhe vezoreve).
Çfarë do të thotë kur treguesit janë të rritur apo fillojnë të bien?
Vlerat e rritura të treguesve mund të sinjalizojnë praninë e kancerit, por jo gjithmonë e konfirmojnë atë. Ato mund të tregojnë për përparim të sëmundjes, përhapje në organe të tjera ose metastaza. Në çdo rast, interpretimi bëhet në kontekstin e gjendjes së pacientit dhe rezultateve të tjera mjekësore.
Nëse vlerat fillojnë të bien, kjo zakonisht nënkupton se trajtimi po funksionon dhe se numri i qelizave tumorale po zvogëlohet. Megjithatë, vlerat mund të luhaten natyrshëm gjatë kohës, edhe gjatë terapisë, prandaj mjekët ndjekin trendin e përgjithshëm, jo një rezultat të vetëm.
Për këtë arsye, vendimet mjekësore nuk bazohen vetëm në tumor markerë, por në kombinimin e analizave laboratorike, imazherike dhe ekzaminimit klinik. /Telegrafi/

















































